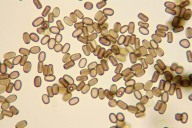

Sajasto odmiranje skorjeTaksonomija
Latinsko ime: Cryptostroma corticale (Ellis & Everh.) P.H. Greg. & S. Waller (1952)
Angleško ime: sooty bark disease of sycamore
Nemško ime: Ahornrindenkrankheit
Klasifikacija: Incertae sedis, Incertae sedis, Pezizomycotina, Ascomycota, Fungi
IndexFungorum
Opis
Osnovni podatki
- Frekvenca: zelo redek
- Skupina organizmov: mikroglive
- Tip bolezni: karantenske bolezni
- Vrsta prehranjevanja: fakultativen parazit
Razširjenost:
Sajasto odmiranje skorje izvira iz Severne Amerike. Prisotna je v sosednji Avstriji (2004) in Italiji (2013). Potrdili so jo tudi v večini držav zahodne in osrednje Evrope: Združeno kraljestvo (1945), Francija (1950), Švica (2003), Češka (2005), Nemčija (2005), Nizozemska (2013). Pojavlja se tudi v Bolgariji (2014). V Sloveniji bolezni še nismo našli.
Biologija:
Gliva se pojavlja v zdravih gostiteljih kot endofit. Zato jo zlahka spregledamo v začetni fazi, ko povzroča odmiranje posameznih vej in vejic v zgornjem delu krošnje. Gliva vstopi v gostitelja skozi rano ali odmrle/odlomljene veje. Na javorjih z odmirajočo krošnjo in prisotnim venenjem smo pozorni na luščenje skorje v obliki pravokotnikov in dolgih pasov (slika 1). Pod odpadajočo skorjo javorja nastaja obilna količina rjavo-črnih trosov (kot saje), ki jih raznaša veter (slika 2). Ko dež trose spere na tla, se koreničnik in okoliške rastline obarvajo črno. Povzroča neznačilno zeleno-rjavo obarvanje lesa (slika 4). Gliva se širi iz lesa v smeri skorje. V normalnih razmerah je neškodljiva, v sušnem in vročinskem stresu pa povzroča obolenje javorov. Zato predvidevamo, da bo v prihodnje zaradi podnebnih sprememb bolezen pogostejša.
Obseg poškodbe:
Vdihovanje trosov povzroča alergije pri ljudeh, tj. vnetje pljučnih mešičkov (ekstrinzični alergijski alveolitis). V normalnih razmerah bolezen povzroča odmiranje vej. Po suhem in vročem poletju lahko bolezen povzroči propad celega drevesa. Povzroča obarvanje jedrovine, zato obolelo drevo zgubi tehnično vrednost.
Del rastline:
Gostitelji:
Razvojna faza:
- debeljak
- drogovnjak
- letvenjak
Simptomi:
- venenje
- sušenje
- odpadanje skorje: v obliki pravokotnikov in dolgih pasov
- trosišča: obilna količina rjavo-črnih trosov pod skorjo
- sprememba barve: neznačilno zeleno-rjavo obarvanje lesa
Viri
Cech T.L. 2004. Bemerkenswerte Krankheiten in 2004. Forstschutz Aktuell 3: 31-34.
Koukol O., Kelnarová I., Černý K. 2015. Recent observations of sooty bark disease of sycamore maple in Prague (Czech Republic) and the phylogenetic placement of Cryptostroma corticale. Forest Pathology, 45, 1: 21-27. Povezava: https://onlinelibrary.wiley.com/doi/abs/10.1111/efp.12129
Bencheva S. 2014. First report of Cryptostroma corticale (Ellis & Everh.) P.H. Greg. & S. Waller on Acer platanoides L. in Bulgaria. Silva Balcanica 15(2): 101-104.
Slikovno gradivo

|

|

|
|
Sajasto odmiranje skorje: obarvana jedrovina, javor (foto. UK Forestry Commission Archive -)
|
Sajasto odmiranje skorje: rjavi trosi (foto. Storey Malcom)
|
Sajasto odmiranje skorje: rjavi trosi (foto. Storey Malcom)
|

|

|

|
|
Sajasto odmiranje skorje: rjavi trosi pod mikroskopom (foto. Storey Malcom)
|
Sajasto odmiranje skorje: skorja se lušči v obliki pasov (foto. Storey Malcom)
|
Sajasto odmiranje skorje: skorja se lušči v obliki pasov (foto. Storey Malcom)
|
|
| |
|
Sajasto odmiranje skorje: skorja se lušči v obliki pasov (foto. Storey Malcom)
|
| |
 na vrh strani
na vrh strani
 na vrh strani
na vrh strani







